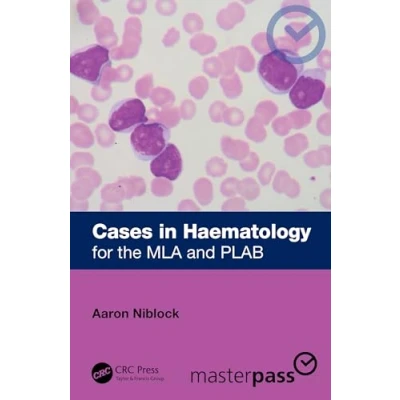

Cases in Haematology: for the MLA and PLAB (MasterPass)
Prices from
COMPARE ALL WEBSHOPS
(2)
Amazon
Cases in Haematology: for the MLA and PLAB (MasterPass)
Read more
26.16
Featured

|
£ 26.16 |
To Shop
|

|
£ 27.54 |
To Shop
|
 Description
Description
Amazon
Cases in Haematology: for the MLA and PLAB (MasterPass)
 Price History
Price History
Prices were last updated on:

Product specifications
Product specifications Related
Related 



